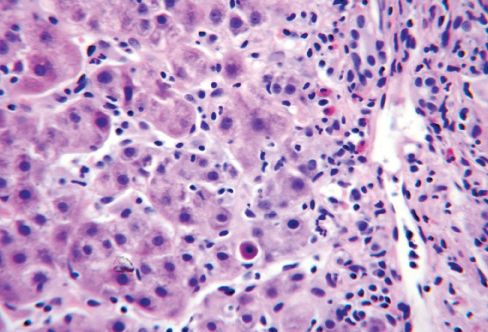
hepatotoxicity

Clopidogrel-Induced Hepatotoxicity
Coronary artery disease was diagnosed in a 39-year-old African American woman with a history of hypertension, hyperlipidemia, and sarcoidosis. She underwent a coronary catheterization with placement of a drug-eluting stent in the left anterior descending artery. Clopidogrel 75 mg/d was prescribed.
One week after the catheterization, the patient began to experience fatigue, nausea, pruritus, jaundice, and increased bruisability on her arms. She presented to the hospital 48 days after the catheterization. She had no fever, chills, or rash; however, she reported right lower quadrant discomfort, which was relieved with defecation. Her stools were gray at presentation, but she denied seeing any blood in the stools. She also denied alcohol consumption and use of acetaminophen or other over-the-counter drugs; she had no family history of liver disease. Earlier in the year her liver function tests had been normal. Her current medications consisted of hydrochlorothiazide, simvastatin, famotidine, aspirin, and clopidogrel.
On admission, vital signs were within normal limits, and physical examination results were significant for mild right upper quadrant tenderness on deep palpation, scleral icterus, and pronounced jaundice. Laboratory studies showed elevation of liver enzymes that was suggestive of mixed hepatocellular and cholestatic liver disease pattern: aspartate aminotransferase (AST), 758 U/L; alanine aminotransferase (ALT), 712 U/L; total bilirubin (TB), 8.3 mg/dL; direct bilirubin (DB), 4.1 mg/dL; albumin, 3.7 g/dL; INR, 1.1; and alkaline phosphatase (AP), 272 U/L; amylase and lipase levels were within normal limits. The patient had been taking 20 mg of simvastatin for 3 years. On admission simvastatin was stopped, but clopidogrel was continued.
During the patient’s hospital stay, her AST level peaked on day 14 at 1797 U/L; ALT, 1954 U/L; TB, 23 mg/dL; DB, 13.1 mg/dL; and AP, 348 U/L. Test results for hepatitis A, B, and C were negative, as were those for Epstein-Barr virus serology (IgM), antimitochondrial antibody, cytomegalovirus serology, anti-smooth muscle antibody, liver/kidney microsomal antibody, antinuclear antibody, and anti-double-stranded DNA antibody. Ceruloplasmin level was 55 mg/dL; transferrin saturation, 35%; and ferritin level, 4300 ng/mL. Alpha-1-antitrypsin phenotype A1AT level was 211 mg/dL.
A radionuclide hepatobiliary scan showed a pattern of severe cholestasis. Ultrasound-guided liver biopsy revealed mild steatosis (less than 5% of parenchyma involved) and hepatitis. There were marked periportal and lobular mixed inflammatory cells, including neutrophils, macrophages, lymphocytes, eosinophils, and scattered plasma cells. Prussian blue and periodic acid-Schiff stains were negative for iron and alpha-1 antitrypsin bodies.
On hospital day 15, clopidogrel was discontinued and ticlopidine was started. Six days later, laboratory studies showed TB, 16.5 mg/dL; DB, 8.1 mg/dL; AP, 214 U/L; AST, 606 U/L; and ALT, 886 U/L. At this time simvastatin was restarted. Transaminase levels continued to decrease, and 26 days after clopidogrel was discontinued, TB was 2.2 mg/dL; AP, 120 U/L; AST, 57 U/L; and ALT, 98 U/L. The patient remained asymptomatic.
Clopidogrel is a highly effective antiplatelet therapy, widely used in atherosclerotic vascular disease, especially after cardiac catheterization. Although it appears to be very safe, it is associated with rare but serious side effects such as hepatotoxicity. The most common side effects are indigestion, nausea, vomiting, diarrhea, bleeding, and rash; however, systemic inflammatory response syndrome, neutropenia, thrombotic thrombocytopenic purpura, febrile neutropenia, aplastic anemia, serum sickness-like reaction, and hepatotoxicity have been reported. Side effects can occur as early as 3 days and as late as 6 months after clopidogrel therapy is started.
It is important to periodically check a complete blood cell count and liver function tests as early as 1 week after clopidogrel is introduced. This drug should be used with caution in patients who have preexisting liver disease. Certainly, if the patient reports jaundice and transaminase levels are elevated, clopidogrel should be discontinued and alternative treatment should be started.
FOR MORE INFORMATION:
•Beltran-Robles M, Marquez Saavedra E, Sanchez-Muñoz D, Romero-Gomez M. Hepatotoxicity induced by clopidogrel. J Hepatol. 2004;40(3):560-562.
•Cassidy LJ, Schuster BG, Halparin LS. Probable ticlopidine-induced cholestatic hepatitis. Ann
Pharmacother. 1995;29(1):30-32.
•Greaney JJ Jr, Hess DA, Mahoney C. Ticlopidine-induced cholestatic jaundice. Clin Pharmacol. 1993;12:398-399.
•Höllmüller I, Stadlmann S, Graziadei I, Vogel W. Clinico-histopathological characteristics of clopidogrel-induced hepatic injury: case report and review of literature.Eur J Gastroenterol Hepatol. 2006;18(8):931-934.
•Klepser TB, Jogrest GJ. Ticlopidine-induced elevated liver function enzymes. Pharmacotherapy. 1997;17(4):819-821.
•Ng JA, Goldberg N, Tafreshi MJ. Clopidogrel-induced hepatotoxicity and fever. Pharmacotherapy. 2006;26(7):1023-1026.
•Product Information. Plavix. New York, NY. Sanofi Pharmaceuticals, Inc, 1997.
•Ruiz-Valverde P, Zafon C, Segarra A, et al. Ticlopidine-induced granulomatous hepatitis. Ann Pharmacother. 1995;29(6):633-634.
